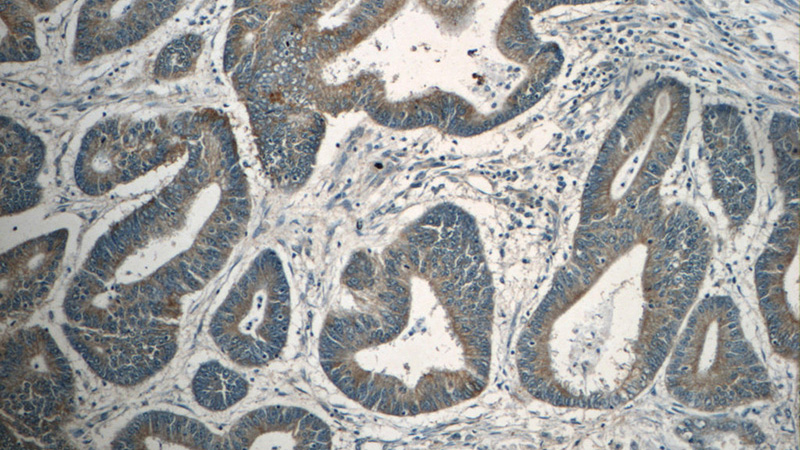
Immunohistochemistry of paraffin-embedded human colon cancer tissue slide using Catalog No:112614(MDK Antibody) at dilution of 1:50 (under 10x lens)

-
Product Name
Midkine antibody
- Documents
-
Description
Midkine Rabbit Polyclonal antibody. Positive IF detected in HepG2 cells. Positive IHC detected in human colon cancer tissue, human liver cancer tissue, human pancreas cancer tissue, human prostate cancer tissue.
-
Tested applications
ELISA, IF, IHC
-
Species reactivity
Human,Mouse,Rat; other species not tested.
-
Alternative names
ARAP antibody; FLJ27379 antibody; MDK antibody; Midkine antibody; MK1 antibody; NEGF2 antibody
-
Isotype
Rabbit IgG
-
Preparation
This antibody was obtained by immunization of Midkine recombinant protein (Accession Number: XM_011520116). Purification method: Antigen affinity purified.
-
Clonality
Polyclonal
-
Formulation
PBS with 0.1% sodium azide and 50% glycerol pH 7.3.
-
Storage instructions
Store at -20℃. DO NOT ALIQUOT
-
Applications
Recommended Dilution:
IHC: 1:20-1:200
IF: 1:20-1:200
-
Validations

Immunofluorescent analysis of HepG2 cells, using MDK antibody Catalog No:112614 at 1:50 dilution and FITC-labeled donkey anti-rabbit IgG (green).
Immunohistochemistry of paraffin-embedded human colon cancer tissue slide using Catalog No:112614(MDK Antibody) at dilution of 1:50 (under 10x lens)

Immunohistochemistry of paraffin-embedded human colon cancer tissue slide using Catalog No:112614(MDK Antibody) at dilution of 1:50 (under 40x lens)
-
Background
MDK represents midkine (neurite growth-promoting factor 2)
-
References
- Bird AD, Choo YL, Hooper SB, McDougall AR, Cole TJ. Mesenchymal glucocorticoid receptor regulates the development of multiple cell layers of the mouse lung. American journal of respiratory cell and molecular biology. 50(2):419-28. 2014.
Related Products / Services
Please note: All products are "FOR RESEARCH USE ONLY AND ARE NOT INTENDED FOR DIAGNOSTIC OR THERAPEUTIC USE"
